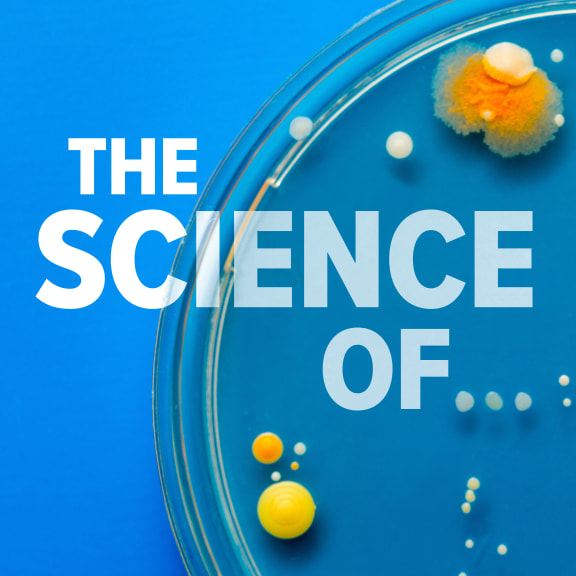
4ks75rs the science of cover internal 2023 png

Search Results
Related tags:
- science
- Sciences
- Science
- Superspy Science: Science
- marine science
- science communication
- forensic science
- citizen science
- Christian Science
- science commercialisation
- data science
- GNS Science
- science show
- exercise science
- science funding
- food science
- social science
- science advice
- Science Explosion
- computer science
- science writing
- behavioural science
- science fiction
- climate science
- science honours
Displaying items 2676 - 2700 of 10000 in total
-
Will NZ follow other countries and get new Covid vaccines? What you need to know
Covid vaccines and new variants: What you need to know
Different countries are using slightly different Covid vaccine - some newer than the ones available in NZ. Does that matter? Audio
-
SIS agent turned freshwater champion Mike Joy
Freshwater ecologist Mike Joy is a controversial figure who says things some people don't want to hear. He came to academia late, after time spent as a mechanic, milkman, truck driver, agent with the… Audio
-
Dr Joëlle Gergis: Pacific Island Forum was lacking in ambition
The Pacific Island forum, which had the theme Transformative Resilient Pasifiki: Build Better Now, wrapped up last week in Tonga. But award-winning Australian climate scientist Dr. Joelle Gergis, who… Audio
-
What you need to know about the draft English and maths curriculums
Should a five-year-old be able to count to 10 and accurately describe shapes?
This is what you need to know about the draft English and maths curriculums out for consultation.
-
Syphilis cases likely to rise if workforce not boosted, specialist says
'Dramatic' increase in babies born with syphilis
Specialists are warning cases with go higher unless the sexual health workforce is boosted. Audio
-
Everything you need to know before seeing the long-awaited Beetlejuice sequel
What to know before seeing the long-awaited Beetlejuice sequel
Decades after cult film Beetlejuice exploded onto our screens, the 'Juice' is loose once again with the sequel: Beetlejuice Beetlejuice.
-
How do I pick the right educational app for my child?
How do I know if an educational app is any good for my child?
There are five benchmarks that parents or educators should look for. Audio
-
What a swab from a tuatara's guts can tell you
Carmen Hoffbeck is a microbiologist at the University of Auckland specialising in the gut microbiome of the mighty tuatara. She joins Emile Donovan. Audio
-
Our Changing World: New Zealand at the Australian Synchrotron
The 'science donut' across the ditch
Scientists at the Australian Synchrotron use intense beams of light to answer research questions
-
Australia plans AI rules on human oversight, transparency
Australia plans AI rules on human oversight, transparency
The government unveiled 10 new voluntary guidelines on AI systems and has opened consultation over whether to make them mandatory.
-
With so many education apps - how can parents know which ones are good?
The phrase "there's an app for that" certainly applies in the education space - one estimate puts numbers available on the Apple and Google Play stores at nearly 400,000. But are they any good? Audio
-
Using devices in bed detrimental to sleep: Study
A new study on the sleeping habits of adolescents says using devices in bed is more detrimental to youth sleep than screen time before bed. Lead author of the Otago University study Dr Bradley Brosnan… Audio
-
The 'science shed' across the ditch
The 'science shed' across the ditchPodcast episode — 04 September 2024Electrons! High speeds! Intense beams of light! Claire Concannon takes a tour of our nearest particle accelerator – the Australian Synchrotron in Melbourne. Designed to create high-energy x-ray light useful for science, the synchrotron enables an incredible diversity of research. And, because of long-standing funding support, New Zealand scientists can also use it. Claire finds out what interesting research questions some visiting New Zealanders are shining a light on.
-
The 'science shed' across the ditch
Audio 5 Sep 2024Electrons! High speeds! Intense beams of light! Claire Concannon takes a tour of our nearest particle accelerator - the Australian synchrotron in Melbourne. Designed to create high-energy x-ray light… Audio
-
Stories from Our Changing World
Claire Concannon visits the Australian synchrotron in Melbourne where intense beams of x-ray light are created for use in science, including some New Zealand research. Audio
-
Australia's Giant Sea Scorpion
Australia is home to some of the deadliest creatures in the world, but it could be worse! Recently, they've discovered a giant sea scorpion which used to stalk the waters... Dr Patrick Smith - a… Audio
-
The New Sex Gene?
The Y chromosome is in decline and there have been fears that humans could become extinct unless we evolve a new sex gene. But in positive news for all of us Japanese researchers have discovered that… Audio
-
Kiwi actually an Australian immigrant, experts say
Kiwi actually an Australian immigrant, experts say
Some species long thought to be native to New Zealand are actually Australian immigrants, new research has found. Audio
-
Species thought to be native to NZ arrived from Australia
New research has found some species long thought to be native to New Zealand - including kiwi, takahe and moa - actually arrived from Australia just a few million years ago. Canterbury Museum's Senior… Audio
-
‘Help us’: Guam's nuclear radiation survivors’ plea to the United States
'Help us': Guam's nuclear radiation survivors' plea to the United States
Sharing their stories for the first time, Guam cancer survivors of the nuclear radiation exposure, want the world to know how it has devastated their lives and their families. Audio
-
When does spring actually start? And what can we expect this season?
When does spring actually start? And what's in store?
Does spring begin on the first day of September? Or does it start on September 23 - the perfect middle point between the winter and summer equinox? Audio
-
Attachment styles are all the rage on TikTok but can they really doom your relationship?
How TikTok gets relationships wrong
You might have got the impression from social media that attachment styles can predict your love life. This take on relationships twists science into "unhelpful nonsense", psychologists say. Video
-
New pāua species found off remote NZ islands
New pāua species found off remote NZ islands
'The pāua that clings to the sea': A new species of abalone found only in waters off Three Kings Islands/Manawatāwhi.
-
The Science Of…
ProgrammeThe Science Of…Presented by Alison Ballance & Simon Morton
The science of everyday things that you’ve always wondered about, with Alison Ballance and Simon Morton. Winner of Best Programme (This Way Up) at 2018 NZ Radio Awards
-
Nanogirl's Great Science Adventures
ProgrammeNanogirl's Great Science AdventuresA science podcast for kids. Answering their burning questions and showing them the wonders of discovery. By RNZ & Nanogirl Labs Ltd. Made possible by the RNZ/NZ On Air Innovation Fund.